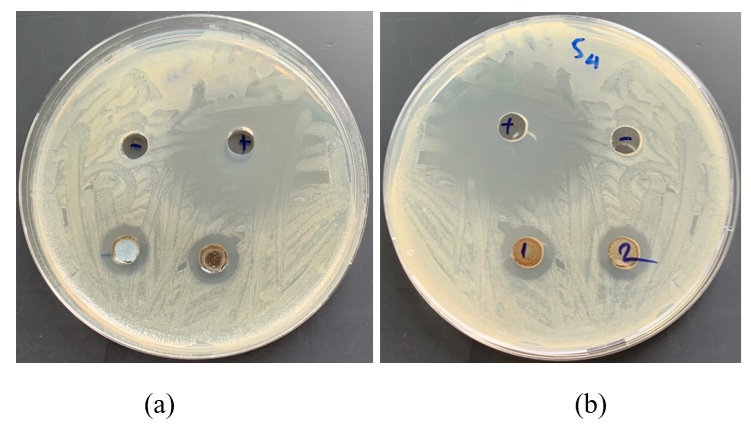
5-1773392126.png

Tóm tắt
Màng Polypropylene (PP) được phủ Graphene oxide (GO) nhằm tăng khả năng kháng khuẩn và giảm bám cặn trên bề mặt màng trong quá trình lọc nước sinh hoạt. GO được tổng hợp bằng phương pháp Hummers cải tiến và phủ lên màng PP đã được xử lý bằng tia UV để tăng độ bám dính. Kết quả cho thấy, GO phân bố đồng đều trên bề mặt màng. Thử nghiệm kháng khuẩn bằng phương pháp đĩa thạch cho thấy màng PP/GO tạo vùng ức chế rõ rệt với đường kính 15,0 mm đối với E. coli và 15,3 mm đối với Salmonella sp., chứng minh lớp phủ GO giúp tăng khả năng loại bỏ vi khuẩn trong nước và hạn chế hiện tượng bám cặn trên bể mặt màng một cách hiệu quả. Đáng chú ý, hiện tượng bám cặn (fouling) là nguyên nhân chính làm giảm thông lượng và tuổi thọ của màng polymer trong xử lý nước [1] [2]. Kết quả nghiên cứu này cho thấy, màng PP/GO không chỉ có khả năng kháng khuẩn hiệu quả mà còn cải thiện rõ rệt khả năng chống bám cặn sinh học, hứa hẹn ứng dụng thực tiễn cao trong lọc nước quy mô hộ gia đình.
Từ khóa: Graphene oxide, chống bám cặn , màng polypropylen, màng PP/GO.
Ngày nhận bài: 15/12/2025; Ngày sửa chữa: 14/1/2026; Ngày duyệt đăng: 20/1/2026.
Evaluating the antibacterial properties of polypropylene membrane coated with graphene oxide (PP/GO)
Abstract
Polypropylene (PP) membranes are coated with graphene oxide (GO) to enhance antibacterial properties and reduce surface scaling during domestic water filtration. GO is synthesized using an improved Hummers method and coated onto the PP membrane, which has been treated with UV radiation to increase adhesion. The results show that GO is evenly distributed across the membrane surface. Antibacterial testing using agar plates showed that the PP/GO membrane created a distinct inhibition zone with a diameter of 15.0 mm for E. coli and 15.3 mm for Salmonella sp., demonstrating that the GO coating effectively enhances bacterial removal in water and reduces surface scaling. Notably, fouling is a major cause of reduced throughput and lifespan of polymer membranes in water treatment. This research shows that PP/GO membranes not only have effective antibacterial properties but also significantly improve biofilm resistance, promising high practical application in household-scale water filtration.
Keywords: Antifouling, Graphene oxide, Polypropylene membrane, PP/GO membrane.
JEL Classifications: Q51, Q52, Q56, Q57.
1. Giới thiệu
Trong những năm gần đây, nhiều nghiên cứu trên thế giới đã chứng minh hiệu quả của vật liệu graphene oxide (GO) trong việc tăng khả năng kháng khuẩn và giảm bám cặn sinh học trên bề mặt màng lọc nước cho thấy, màng polymer phủ GO có khả năng hạn chế biofouling và tăng độ ưa nước [3]. Các nghiên cứu khác như của Mohammad Y. Ashfaq [4] và Liu (2018) [5] cũng khẳng định rằng lớp phủ GO giúp ức chế sự phát triển của vi sinh vật và duy trì hiệu suất lọc ổn định. Những kết quả này tạo nền tảng vững chắc cho việc ứng dụng màng PP/GO trong nghiên cứu hiện tại.
Màng polypropylene là màng phổ biến được sử dụng trong lọc nước cấp cho sinh hoạt mang lại hiệu quả cao, tuy nhiên màng PP dễ bị bám cặn trên bề mặt do các vi khuẩn bám trên màng gây tắt nghẽn và giảm hiệu suất lọc. GO là vật liệu nano tiên tiến với nhiều ưu điểm vượt trội, kháng khuẩn là một trong những ưu điểm của vật liệu này, do đó nhóm nghiên cứu tiến hành phủ GO lên màng PP bằng phương pháp phủ bề mặt nhằm tăng cường khả năng kháng khuẩn và chống hiện tượng bám cặn trên bề mặt màng do đó tăng tuổi thọ của màng
Từ những cơ sở đó, nghiên cứu này hướng tới tạo màng Polypropylene (PP) được xử lý tia UV và phủ Graphene oxide (PP/GO) nhằm nâng cao hiệu suất khử mặn, giảm fouling và tiêu thụ năng lượng, mở ra triển vọng ứng dụng thực tiễn trong lọc nước quy mô hộ gia đình.
2. Đối tượng và phương pháp nghiên cứu
2.1. Tổng hợp Graphene oxide
GO được tổng hợp theo phương pháp Hummers cải tiến [3]. Cụ thể, than chì được khuấy trong hỗn hợp H₂SO₄:H3PO4 tỷ lệ 1:9 nhiệt độ trong dung dịch được duy trì trong khoảng 0-5°C, sau đó thêm từ từ KMnO₄ và tiếp tục phản ứng dưới điều kiện kiểm soát nhiệt độ, khuấy liên tục 6h. Sau khi phản ứng hoàn tất, hỗn hợp được xử lý bằng H₂O₂ để dừng phản ứng, rửa bằng HCl loãng và nước cất cho đến pH trung tính. Sản phẩm GO được ly tâm, sấy khô để sử dụng cho các thí nghiệm tiếp theo.
2.2. Phủ màng
Màng PP thương mại (độ dày 50 µm) được xử lý tia UV ở bước sóng 365 nm, cường độ 1.8 mW/cm² trong 30 phút nhằm tăng năng lượng bề mặt và hình thành các nhóm oxy hoạt tính (C=O, –OH) nhằm tăng hiệu quả bám dính. Sau xử lý, màng được ngâm trong dung dịch GO 0,1% trong 2 giờ ở nhiệt độ phòng để lớp GO bám đồng đều trên bề mặt, sau đó sấy ở 60°C trong 12 giờ để cố định cấu trúc. Màng phủ hoàn thiện (PP/GO) được rửa nhẹ bằng nước cất để loại bỏ GO tự do và bảo quản trong điều kiện khô.
2.3. Đánh giá khả năng kháng khuẩn bề mặt màng
Khả năng kháng khuẩn của màng được xác định đối với chủng vi khuẩn E.coli bằng phương pháp khuếch tán trên đĩa thạch (agar diffusion method). Mẫu màng PP nguyên bản và màng PP phủ Graphene oxide (PP/GO) được cắt thành các đĩa tròn đường kính 5 mm, sau đó đặt trực tiếp lên bề mặt đĩa thạch đã được cấy đều vi khuẩn E. coli, salmonella trong môi trường dinh dưỡng LB.
Các đĩa thạch được ủ ở 37°C trong 24 giờ, sau đó quan sát và đo đường kính vùng ức chế vi khuẩn (inhibition zone) xung quanh mẫu màng bằng thước kẹp kỹ thuật số (độ chính xác 0,01 mm). Mẫu có đường kính vùng ức chế lớn hơn thể hiện hoạt tính kháng khuẩn mạnh hơn.
2.4. Đánh giá hiệu quả lọc của màng
Thí nghiệm được tiến hành với nước giả định pha với nồng độ vi sinh 106. Mẫu nước được lọc qua màng Polypropylene phủ Graphene oxide (PP/GO) trong điều kiện áp suất khí quyển, theo mô hình lọc trọng lực. Thông lượng nước đạt 30 L·m⁻²·h⁻¹, cho thấy màng có khả năng thấm nước tốt nhờ lớp phủ GO ưa nước. Kiểm vi sinh bằng phương pháp đĩa thạch theo TCVN 6187-2:2020 (ISO 9308-2:2012).
Quy trình xử lý nước sông thành nước sinh hoạt gồm các bước chính như sau: Nước thô được dẫn vào bể trung hòa, tại đây bổ sung chất trung hòa và khử trùng sơ bộ để ổn định pH và giảm vi sinh vật. Sau đó, nước chuyển sang bể keo tụ – tạo bông, nơi châm phèn nhôm để kết dính các hạt cặn nhỏ thành bông cặn lớn. Tiếp theo, nước chảy vào bể lắng để tách bông cặn ra khỏi nước, phần bùn lắng được loại bỏ định kỳ. Nước trong tiếp tục qua hệ thống lọc thô, lọc tinh và lọc PHGOM nhằm loại bỏ cặn mịn và vi sinh. Cuối cùng, nước sạch được thu vào bình chứa, sẵn sàng cung cấp cho sinh hoạt sau khi kiểm tra đạt tiêu chuẩn chất lượng.

3. Kết quả biện luận
3.1. Tổng hợp graphene oxide

Hình 2, trình bày ảnh FESEM của mẫu Graphene oxide (GO) tổng hợp theo phương pháp Hummers cải tiến. Quan sát ở độ phóng đại 50.000× cho thấy, các tấm GO mỏng, có cấu trúc dạng lớp xếp chồng (lamellar structure) và nếp gấp uốn nhẹ, đặc trưng cho vật liệu graphene đã oxy hóa. Hình b cho thấy các lớp GO có chiều dày nano–micromet, phân bố không đồng đều, một số vùng xuất hiện các nếp gấp và gờ nhăn do sự bóc tách từng phần trong quá trình rửa và sấy. Trong khi đó, ảnh bên phải cho thấy các tấm GO mỏng hơn, chồng xen kẽ tạo thành cấu trúc xếp lớp song song, chứng tỏ quá trình oxy hóa graphite đã diễn ra hoàn toàn, tạo ra các tấm graphene đơn hoặc vài lớp có độ mỏng cao. Hình thái này cho thấy, GO được tổng hợp thành công, có độ bóc tách tốt và tính đồng nhất cao, thích hợp cho quá trình phủ màng Polypropylene (PP) nhằm tăng độ ưa nước và hiệu suất khử muối trong ứng dụng lọc nước.

Phổ FTIR của mẫu Graphene oxide (GO) cho thấy, các đỉnh đặc trưng tại 3437 cm⁻¹ (O–H), 1629 cm⁻¹ (C=O), 1213 cm⁻¹ (C–O–C) và 598 cm⁻¹ (C–O), chứng tỏ sự hình thành thành công của các nhóm chức oxy hóa trên bề mặt GO. Sự xuất hiện đồng thời của các nhóm hydroxyl, carbonyl và epoxy xác nhận quá trình oxy hóa graphite diễn ra hiệu quả, tạo nên vật liệu GO có độ phân tán và hoạt tính bề mặt cao, thích hợp cho phủ lên màng PP nhằm tăng độ ưa nước và khả năng liên kết bề mặt.
Phổ UV–Vis của mẫu Graphene oxide (GO) thể hiện một đỉnh hấp thụ mạnh tại khoảng 230 nm, tương ứng với chuyển dời điện tử π→π* của liên kết C=C trong khung sp² của graphene, cùng với vai hấp thụ kéo dài khoảng 300 nm do chuyển dời n→π* của nhóm C=O. Sự hiện diện của hai dải hấp thụ đặc trưng này khẳng định quá trình oxy hóa graphite đã diễn ra thành công, tạo nên cấu trúc GO có chứa các nhóm chức oxy hóa trên bề mặt.
3.2. Kết quả phủ màng

Hình 4 cho thấy, kết quả ảnh FESEM của màng Polyropylene (PP) sau khi phủ Graphene oxide (GO). Ở cả hai độ phóng đại, có thể quan sát rõ các tấm GO phân bố không đồng đều, bám xen giữa các sợi polymer của màng PP. Một số vùng thể hiện GO phủ bám chặt và lan rộng dọc theo bề mặt sợi, chứng tỏ tương tác liên kết giữa nhóm chức oxy trên GO và bề mặt PP đã xử lý UV là hiệu quả. Các lớp GO mỏng bao phủ cục bộ giúp tăng độ ưa nước và tạo các đường dẫn vận chuyển nước, trong khi vẫn duy trì cấu trúc xốp của PP. Kết quả này xác định quá trình phủ GO lên màng PP thành công, tạo nên vật liệu lai PP/GO có cấu trúc ổn định và bề mặt hoạt hóa cao.
3.3. Đánh giá khả năng kháng khuẩn bề mặt màng
Hình 5 thể hiện khả năng kháng khuẩn của màng PP phủ Graphene oxide (PP/GO) sau khi lọc nước lợ. Màng thể hiện vòng ức chế rõ rệt xung quanh mẫu đối với cả hai chủng vi khuẩn: E.coli vòng kháng khuẩn có đường kính 15,0 mm và Salmonella sp là 15,3 mm (SD: ±0.21 mm). Kết quả chứng minh rằng tính kháng khuẩn của lớp phủ GO vẫn được duy trì sau quá trình vận hành lọc, nhờ sự hiện diện của các nhóm oxy hoạt tính và cạnh sắc GO có khả năng phá vỡ màng tế bào vi khuẩn. Điều này khẳng định tiềm năng của màng PP/GO trong việc chống bám bẩn sinh học (biofouling) và kéo dài tuổi thọ màng trong ứng dụng xử lý nước cấp cho sinh hoạt.
3.4. Đánh giá khả năng lọc nước của màng PP/GO
Kết quả lđánh giá khả năng loại bỏ vi khuẩn của màng PP/GO: Mẫu nước sau khi lọc qua màng PP/GO cho thấy vi sinh vật hầu như không phát hiện được, chứng tỏ màng có khả năng kháng khuẩn và loại bỏ vi sinh hiệu quả. Với lưu lượng đạt 30 L·m⁻²·h⁻¹, màng PP/GO đáp ứng tốt nhu cầu lọc nước sinh hoạt quy mô hộ gia đình, đồng thời cho thấy tiềm năng ứng dụng thực tế cao trong xử lý nước sạch an toàn.
Kết quả xây dựng mô hình lọc nước mặt: Nước sau xử lý các chỉ tiêu đều đạt theo QCVN 01-1:2018/BYT
Bảng 1. Các chỉ tiêu nước sau lọc
|
Nhóm chỉ tiêu |
Thông số |
Mẫu trước lọc |
Màng PP |
Màng PP-GO |
Giới hạn cho phép (QCVN 01-1:2018/BYT) |
|
Vật lý |
Độ đục |
5.2 |
1.25 |
0.20NTU |
≤ 2 NTU |
|
|
Màu sắc |
35 |
17 |
|
≤ 15 TCU |
|
|
Mùi, vị |
không |
không |
Ko |
Không có mùi, vị lạ |
|
|
pH |
7.5 |
7.2 |
7.0 |
6.5 – 8.5 |
|
Hóa học |
Amoni (NH₄⁺) |
0.25 |
KPH (LOD 0.02 mg/L) |
KPH (LOD 0.02 mg/L) |
≤ 0.3 mg/L |
|
|
Nitrat (NO₃⁻) |
35 |
KPH (LOD 0.5 mg/L) |
KPH (LOD 0.5 mg/L) |
≤ 50 mg/L |
|
|
Sắt (Fe) |
0.18 |
KPH (LOD 0.01mg/L) |
KPH (LOD 0.01mg/L) |
≤ 0.3 mg/L |
|
|
Mangan (Mn) |
0.01 |
KPH (LOD 0.005 mg/L) |
KPH (LOD 0.005 mg/L) |
≤ 0.1 mg/L |
|
|
Asen (As) |
0.005 |
KPH (LOD 0.001 mg/L) |
KPH (LOD 0.001 mg/L) |
≤ 0.01 mg/L |
|
|
Chì (Pb) |
0.004 |
KPH (LOD 0.001 mg/L) |
KPH (LOD 0.001 mg/L) |
≤ 0.01 mg/L |
|
|
Tổng chất rắn hòa tan (TDS) |
320 |
8 |
0 |
≤ 1000 mg/L |
|
Vi sinh |
E. coli |
10^3 |
KPH |
KPH |
0 /100 mL |
|
|
Coliform tổng |
10^2 |
KPH |
KPH |
0 /100 mL |
Kết quả quan sát hình thái bề mặt bằng kính hiển vi điện tử quét (SEM) cho thấy, bề mặt màng hoàn toàn sạch, không xuất hiện bất kỳ cấu trúc hay dấu hiệu nào của sự bám dính vi sinh vật. Ngược lại màng PP đối chứng có vi sinh vật bám trên bề mặt màng. Điều này chứng tỏ màng có khả năng chống bám sinh học tốt, hạn chế sự phát triển của vi khuẩn và duy trì hiệu suất lọc ổn định trong quá trình vận hành.

Hình 6. Ảnh SEM của màng PP-GO và màng PP đối chứng sau khi lọc
4. Kết luận
Kết quả nghiên cứu cho thấy, màng PP/GO được tổng hợp bằng phương pháp phủ lớp graphene oxide (GO) lên bề mặt màng PP cho hiệu quả lọc cao, với các chỉ tiêu chất lượng nước sau xử lý đều đạt giới hạn cho phép theo QCVN 01-1:2018/BYT, chứng tỏ khả năng loại bỏ tạp chất và đảm bảo an toàn cho nước sinh hoạt. Bên cạnh đó, màng PP/GO còn thể hiện tính kháng khuẩn vượt trội so với màng PP nguyên bản, với đường kính vòng kháng khuẩn đạt 15–15.3 mm đối với hai chủng E. coli và Salmonella, khẳng định vai trò của GO trong việc tạo ra các phản ứng oxy hóa và phá vỡ cấu trúc màng tế bào vi khuẩn. Hiệu suất lọc của màng PP-GO > 98% với lưu lượng 30 L·m⁻²·h⁻¹ phù hợp với mục đích lọc nước cho hộ gia đình.
Phạm Thị Phương Duyên1, Nguyễn Văn Phước2*
1Trung tâm Công nghệ Sinh học TP. Hồ Chí Minh
2Liên hiệp các hội Khoa học Kỹ thuật TP. Hồ Chí Minh
TÀI LIỆU THAM KHẢO
1. M. A. A.-G. N. Z. Mohammad Y. Ashfaq, "Investigating the effect of polymer-modified graphene oxide coating on RO membrane fouling," Journal of Water Process Engineering, vol. 49, 2022.\
2. L.-j. H. H.-j. Q. Y.-x. W. Z.-j. Z. Q.-l. R. Z.-q. S. Y. W. M. J. K. J.-g. T. Zhen-yang Han, "A review of performance improvement strategies for graphene oxide-based and graphene-based membranes in water treatment," Journal of Materials Science, vol. 56, p. 9545–9574, 2021.
3. N.I. Zaaba, K.L. Foo, U. Hashima S.J.Tan, Wei-Wen Liua, C.H. Voon, "Synthesis of Graphene Oxide using Modified Hummers Method: Solvent Influence," Advances in Material & Processing Technologies Conference, pp. 469 - 477, 2017.
4. Amal Elzubair, Lucas Riley Uchôa, Marcelo Henrique Prado da Silva, "Production and characterization of graphene oxide/polymer support composite membranes for water desalination and purification," Desalination and Water Treatment, vol. 317, 2024.
5. "Investigating the effect of polymer-modified graphene oxide coating on RO membrane fouling," Journal of Water Process Engineering, vol. 49, 2022.
6. Haddadi Majid, Nima Heidarzadeh, Vahid Vantanpour, Ahmad Dehqan, "Surface modification of commercial reverse osmosis membranes using both hydrophilic polymer and graphene oxide to improve desalination efficiency," Chemosphere, vol. 302, 2022